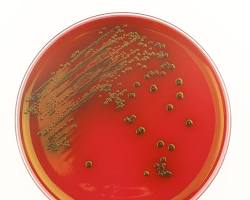
Aerobic Bacterial Culture & Sensitivity (Routine)

Uncategorized
Showing 19–27 of 350 results
-
Uncategorized
AFB Culture L.J Media
₹1,500.00Original price was: ₹1,500.00.₹1,299.00Current price is: ₹1,299.00. -
Uncategorized
Alanine Transaminase (ALT/SGPT)
₹250.00Original price was: ₹250.00.₹199.00Current price is: ₹199.00. -
Uncategorized
Albert Stain/Smear For Diptheria
₹400.00Original price was: ₹400.00.₹350.00Current price is: ₹350.00. -
Uncategorized
Alcohol Serum
₹1,600.00Original price was: ₹1,600.00.₹999.00Current price is: ₹999.00. -
Uncategorized
Aldesterone Renin Ratio (ARR)
₹10,500.00Original price was: ₹10,500.00.₹8,100.00Current price is: ₹8,100.00.